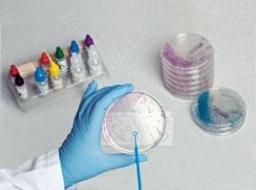

Thermo Scientific GBS Agar Base
Culture media is the foundation of all microbiological testing and determines the quality of the results that follow, whether you're aiding the diagnosis of infection or helping to ensure products are free from pathogens. The Thermo Scientific Oxoid GBS Agar Base (Group B Streptococci Medium) (Islam) is used for the isolation and detection of Group B streptococci in clinical specimens.

The supplier does not provide quotations for this product through SelectScience. You can search for similar products in our Product Directory.
This is an excelent product, I recommend it. We will use it again in the near future.
Molecular entomology
This is an excelent product, I recommend it. We will use it again in the near future.
Review Date: 21 May 2021 | Thermo Fisher Scientific
Culture media is the foundation of all microbiological testing and determines the quality of the results that follow, whether you're aiding the diagnosis of infection or helping to ensure products are free from pathogens.
The Thermo Scientific Oxoid GBS Agar Base (Group B Streptococci Medium) (Islam) is used for the isolation and detection of Group B streptococci in clinical specimens.
Prepared media guide
In this guide, Thermo Fisher Scientific showcases a comprehensive portfolio of solutions for the isolation, identification, differentiation, and susceptibility testing of microorganisms.
Guidelines for the evaluation of commercially prepared culture media
Evaluation of each medium may require different procedures. It is recommended that you should check with your accrediting body for guidance regarding the evaluation required for your laboratory when switching to a different commercial manufacturer.
In this application note, Thermo Fisher Scientific presents a suggested procedure for evaluating media, intended to be modified as required by your laboratory requirements.